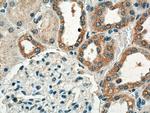
CRTAP Antibody in Immunohistochemistry (Paraffin) (IHC (P))

Search
Proteintech
CRTAP Polyclonal Antibody
{{$productOrderCtrl.translations['antibody.pdp.commerceCard.promotion.promotions']}}
{{$productOrderCtrl.translations['antibody.pdp.commerceCard.promotion.viewpromo']}}
{{$productOrderCtrl.translations['antibody.pdp.commerceCard.promotion.promocode']}}: {{promo.promoCode}} {{promo.promoTitle}} {{promo.promoDescription}}. {{$productOrderCtrl.translations['antibody.pdp.commerceCard.promotion.learnmore']}}
图: 1 / 16
CRTAP Antibody (15724-1-AP) in ICC/IF

产品信息
15724-1-AP
种属反应
宿主/亚型
分类
类型
抗原
偶联物
形式
浓度
规格
纯化类型
保存液
内含物
保存条件
运输条件
产品详细信息
Immunogen sequence: HALDKYSGE HWAESVGYLE ISLRLHRLLR DSEAFCHRNC SAAPQPEPAA GLASYPELRL FGGLLRRAHC LKRCKQGLPA FRQSQPSRDV LADFQRREPY KFLQFAYFKA NNLPKAIAAA HTFLLKHPDD EMMKRNMAYY KSLPGAEDYI KDLETKSYES LFIRAVRAYN GENWRTSITD MELALPDFFK AFYECLAACE GSREIKDFKD FYLSIADHYV EVLECKIQCE ENLTPVIGGY PVEKFVATMY HYLQFAYYKL NDLKNAAPCA VSYLLFDQND KVMQQNLVYY QYHRDTWGLS DEHFQPRPEA VQFFNVTTLQ KELYDFAKEN IMDDDEGEVV EYVDDLLELE ETS (50-401 aa encoded by BC008745)
靶标信息
The protein encoded by this gene is similar to the chicken and mouse CRTAP genes. The encoded protein is a scaffolding protein that may influence the activity of at least one member of the cytohesin/ARNO family in response to specific cellular stimuli. Defects in this gene are associated with osteogenesis imperfecta, a connective tissue disorder characterized by bone fragility and low bone mass.
仅用于科研。不用于诊断过程。未经明确授权不得转售。
篇参考文献 (0)
生物信息学
蛋白别名: Cartilage-associated protein; leprecan-like 3; prolyl 3-hydroxylase family member 5 (non-enzymatic); unnamed protein product
基因别名: 5730529N23Rik; CASP; CRTAP; LEPREL3; OI7; P3H5; RGD1565180
UniProt ID: (Human) O75718, (Mouse) Q9CYD3
Entrez Gene ID: (Human) 10491, (Rat) 363158, (Mouse) 56693




